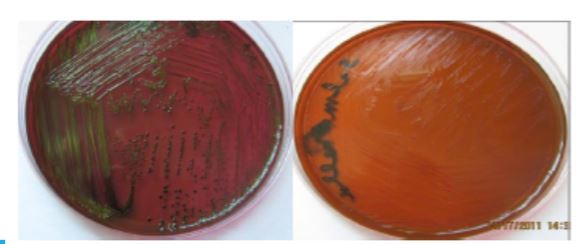
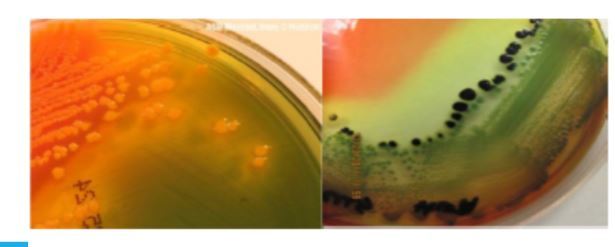
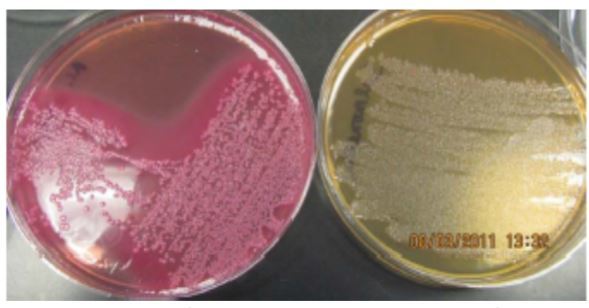
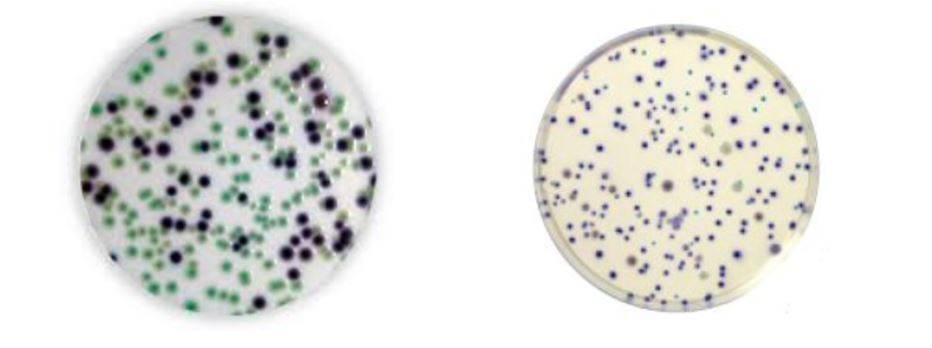
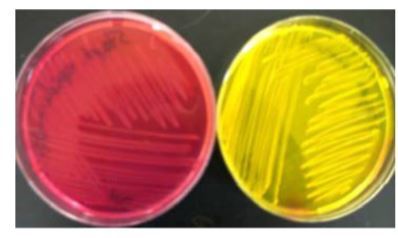

Amikacin (AK)
Sensitive?
Intermediate?
Resistant?
Sensitive =< 16
Intermediate 32
Resistant =>64
Ciprofloxacin (CIP)
Sensitive?
Intermediate?
Resistant?
Sensitive =<1
Intermediate 2
Resistant =>4
Streptomycin
Sensitive?
Intermediate?
Resistant?
Sensitive <16
Intermediate N/A
Resistant >32
Vancomycin (VA)
Sensitive?
Intermediate?
Resistant?
Vancomycin (VA)
Sensitive <4
Intermediate 8-16
Resistant >32
What is the measurement used in zone of inhibition?
mm in diameter
What are the results of this TSI agar

The bacteria fermented the glucose and either the sucrose or lactose (or both),
resulting in a yellow slant and butt (entire medium is yellow).
*The phenol red
turns yellow due to the acid byproducts, indicating fermentation.
For TSI when the butt is yellow and the slant is pink, it means
that the bacteria fermented the glucose but
were unable to use the sucrose or lactose.
What does this mean for TSI

• After depleting the glucose, the bacteria used the amino acids for food (a process is called
peptonization), which produces ammonia and makes the local pH more alkaline.
What does this mean for TSI

If the butt and slant are red (K/K), it means that the bacteria did not ferment any of the sugars and
only the peptones were used.
*his indicates that either the bacteria are not Enterobacteriaceae or a process known as alkaline
reversion/conversion occurred.
What does this mean for TSI

In addition to sugar fermentation and peptonization, bacteria may reduce sulfate for
anaerobic respiration, producing H2S gas. The medium contains ferrous sulfate to detect H2S
gas production (turns black).
What does this mean for SIM?

Left - bacteria reduced sulfur
Right - bacteria do not reduce sulfur
What does this mean for SIM?

Left - then the bacteria did not produce indole (did not break down
tryptophan).
RIGHT - bacteria can metabolize tryptophan and produce indole.
What does this mean for SIM?

LEFT - Motile
RIGHT - Not motile
What does this mean for Simmons citrate?

LEFT - BLUE = Positive
RIGHT - GREEN = Negative
What does this mean for Urea agar?

PINK = POSITIVE
TAN - NEGATIVE
What does this mean for Eosin Methylene Blue?
LEFT - Lactose fermentation - COLIFORM POSITIVE - PINK/PURPLE -ECOLI
metallic green colonies if rapid lactose fermenters
RIGHT - No lactose fermentation - COLIFORM NEGATIVE - ORANGE- SALMONELLA
What does this mean for Hektoen Enteric Agar?
LEFT - Lactose fermentation - yellow-pinkish orange - ECOLI - COLIFORM
RIGHT - Non-lactose fermentation - blue-green SALMONELLA - NON COLIFORM
Hydrogen sulfide production - black
What does this mean for MacConkey Agar
LEFT- Lactose fermination - E COLI - PINK
RIGHT - No Lactose ferminatation - TAN
What does this mean for rapid Ecoli agar?
LEfT - (GAL+/GLUC-) form blue/green colonies;
RIGHT - GAL+/GLUC+) from violet
to pink colonies. - E COLI
What does it mean for agglutination

RIGHT - NEGATIVE
LEFT - POSITIVE
What does this mean for Mannitol?
LEFT - NEGATIVE (S. epidermidis)
RIGHT - POSITIVE YELLOW (S. Aureus & S. Saprophyticus)
What staphylococcus is positive and negative for hemolyiss

S. aureus - POSITIVE - beta, complete lysis
S. sap & epi = Negative, gamma
What does this mean for coagulase?
What S are positive & negative?

TOP - POSITIVE - S. aureus
BOTTOM - NEGATIVE - S. epi & S. sap


